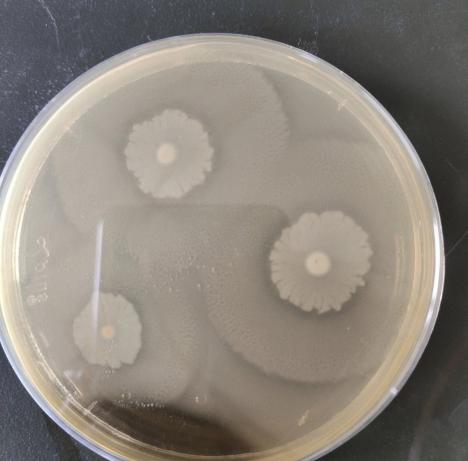

1.奇异变形杆菌(Proteus mirabilis)
物种名:奇异变形杆菌
拉丁学名:Proteus mirabilis
分类学地位:细菌界Bacteria;变形菌门Proteobacteria;
γ-变形菌纲Gammaproteobacteria;肠杆菌目Enterobacterales;
摩根菌科Morganellaceae;变形杆菌属Proteus
奇异变形杆菌是一种革兰氏阴性杆菌,广泛存在于土壤、污水及人和动物的肠道中。它是医院获得性感染(尤其是尿路感染、伤口感染)的常见病原菌,以其独特的“迁徙生长”现象和强尿素酶活性著称。
1.1生物学特性
1.1.1培养特征
奇异变形杆菌是一种革兰氏阴性杆菌,机体被感染后主要表现为尿路感染、菌血症、腹膜炎和脑膜炎等[1]。奇异变形杆菌是兼性厌氧菌,在普通营养琼脂和血琼脂上生长良好。特征性迁徙现象:在湿润琼脂表面呈同心圆状扩散生长(游走swarm),形成薄层菌膜(图1)。在麦康凯琼脂上形成无色菌落(不发酵乳糖),SS琼脂上中心呈黑色(产H₂S)。具有浓烈腐胺气味。
图1 奇异变形杆菌培养结果
1.1.2形态学特征
菌体为直或略弯的杆状,大小0.4-0.6 µm × 1.0-3.0 µm,两端钝圆,革兰阴性,无芽孢、无荚膜[2]。周鞭毛6-10根,运动极其活泼;扫描电镜下可见表面菌毛,介导黏附。

图2 奇异变形杆菌形态特征
1.1.3生化特征
氧化酶阴性,接触酶阳性;苯丙氨酸脱氨酶、尿素酶、明胶酶、H₂S产生均阳性;吲哚阴性(与P. vulgaris区分要点);不发酵乳糖、蔗糖、甘露醇,可发酵葡萄糖产酸产气。
1.1.4分子生物学特征
基因组大小约4.0-4.3 Mb,GC含量38-40%;16S rRNA基因与变形杆菌属模式株同源性≥99%,常用鉴定靶标为16S rRNA、zapA(丝氨酸蛋白酶基因)、ureC(尿素酶结构基因)及rpoB基因;MLST将全球流行株主要归于ST15、ST67、ST100等序列型[3]。毒力岛携带mrkD(Ⅲ型菌毛黏附素)、zapA、rsbA、pmfA等,可介导生物膜形成、结晶尿结石及宿主细胞侵袭。
1.2分布、传播与致病性
1.2.1分布与传播
奇异变形杆菌广泛存在于人和动物肠道、污水、土壤、医院下水道;可在水中存活数周至数月。传播途径包括:粪-口途径:污染饮用水、游泳池水、透析用水;接触途径:经导尿管、伤口或黏膜入侵;空气气溶胶或医护人员手传播,导致医院内暴发[4]。
1.2.2致病性
为医院获得性尿路感染(CAUTI)首要病原之一,尿素酶分解尿素产氨,使尿液碱化,诱导磷酸镁铵结晶形成“鹿角形”结石,引起导管阻塞、反复感染。免疫低下者可并发急性肾盂肾炎、败血症、肺炎、创面坏疽;急性肾盂肾炎病死率5-20%,新生儿或老年脓毒症可达30%。动物模型腹腔攻毒LD₅₀≈6.7×10⁸ CFU,提示高剂量方可致死,但对免疫抑制宿主致病力显著增强。
1.3检测方法
膜过滤-倾注培养法(定量)[5]
适用范围:饮用水、源水、泳池水、污水等环境水样中奇异变形杆菌的定量检测。
操作原理:
(1)水样经0.45 µm无菌滤膜负压过滤,菌体截留于膜面;
(2)将滤膜菌面朝上贴于SS琼脂(或麦康凯琼脂)平板;
(3)36℃±1℃培养18-24 h;
(4)计数无色(或淡黄)、光滑、边缘整齐的可疑菌落,结果以CFU/100 mL报出;
(5)挑取可疑菌落做氧化酶、吲哚、尿素酶、明胶液化等生化确证试验,符合者为奇异变形杆菌。
1.4典型案例
2020年6月,广西某高中南校区水源性腹泻暴发[6]。危害:南校区1800名学生中,先后312人出现急性腹泻、腹痛,无死亡。病原菌是否超标:校内4号自备水井与蓄水池检出奇异变形杆菌,其中4号水井菌落总数1.18×10⁴ CFU/mL、蓄水池2.1×10³ CFU/mL,均远高于《生活饮用水卫生标准》GB 5749-2006限值(菌落总数≤100 CFU/mL),判定“严重超标”。处置结果:当地卫健局对学校罚款5万元,并责令立即停用全部自备水源;校方48 h内完成管网排空、0.5%过氧乙酸循环消毒3次,连续7天检测阴性后恢复市政供水;对两名后勤责任人给予行政记过处分。
1.5防治对策
(1)透析、泳池、自来水系统定期监测细菌总数与奇异变形杆菌qPCR。
(2)对产尿素酶阳性菌株及时更换或酸化导尿管,减少结晶形成。
(3)医院供水系统采用0.2 µm过滤+UV或臭氧消毒,保持末端余氯0.3-0.5 mg/L。
1.6危害等级与标准限值
(1)危害等级
奇异变形杆菌(Proteus mirabilis)在《人间传染的病原微生物名录》及WHO《Laboratory Biosafety Manual》中被归入Risk Group 2(危害程度第二类),对应实验室生物安全等级为BSL-2;动物感染实验需ABSL-2[7]。
(2)标准限值
中国:GB 3838-2021、GB 5749-2022未设该菌限值;可套用GB 4789.10-2016(膜过滤)或GB/T 38774-2020(qPCR)。
欧盟:无专属限量,推荐EN ISO 16266-2(膜过滤)或EN ISO 15216-1(qPCR)。美国:EPA Method 1600(膜过滤)或Method 1611(qPCR)。
WHO:无专属限量,建议暴发时用qPCR(zapA)检测。
参考文献
[1]何敏敏, 厉世笑, 秦佳佳 等. 奇异变形杆菌和解脲支原体混合感染致孕妇感染性休克1例. 中国乡村医药, 2025, 32: 43-44.
[2]李秀彬, 陈萌莉, 杨东霞 等. 一起奇异变形杆菌食物中毒的病原学鉴定. 中国食品卫生杂志, 2002, 14: 2.
[3] Chakkour M, Hammoud Z, Farhat S et al. Overview of Proteus mirabilis pathogenicity and virulence. Insights into the role of metals. Front Microbiol, 2024, 15: 1383618.
[4] https://www.eoucell.com/trends/eocl-w-8289.html
[5] SN/T 2552.8-2010 乳及乳制品卫生微生物学检验方法
[6] 王岩, 贾永华, 汪峰 等. 一起学校饮用水污染造成群体性腹泻的调查. 中国学校卫生, 2018, 39: 2.
[7] O’Hara CM, Brenner FW, Miller JM. Classification, identification, and clinical significance of Proteus, Providencia, and Morganella. Clin Microbiol Rev, 2000, 13: 534-546
.png)
